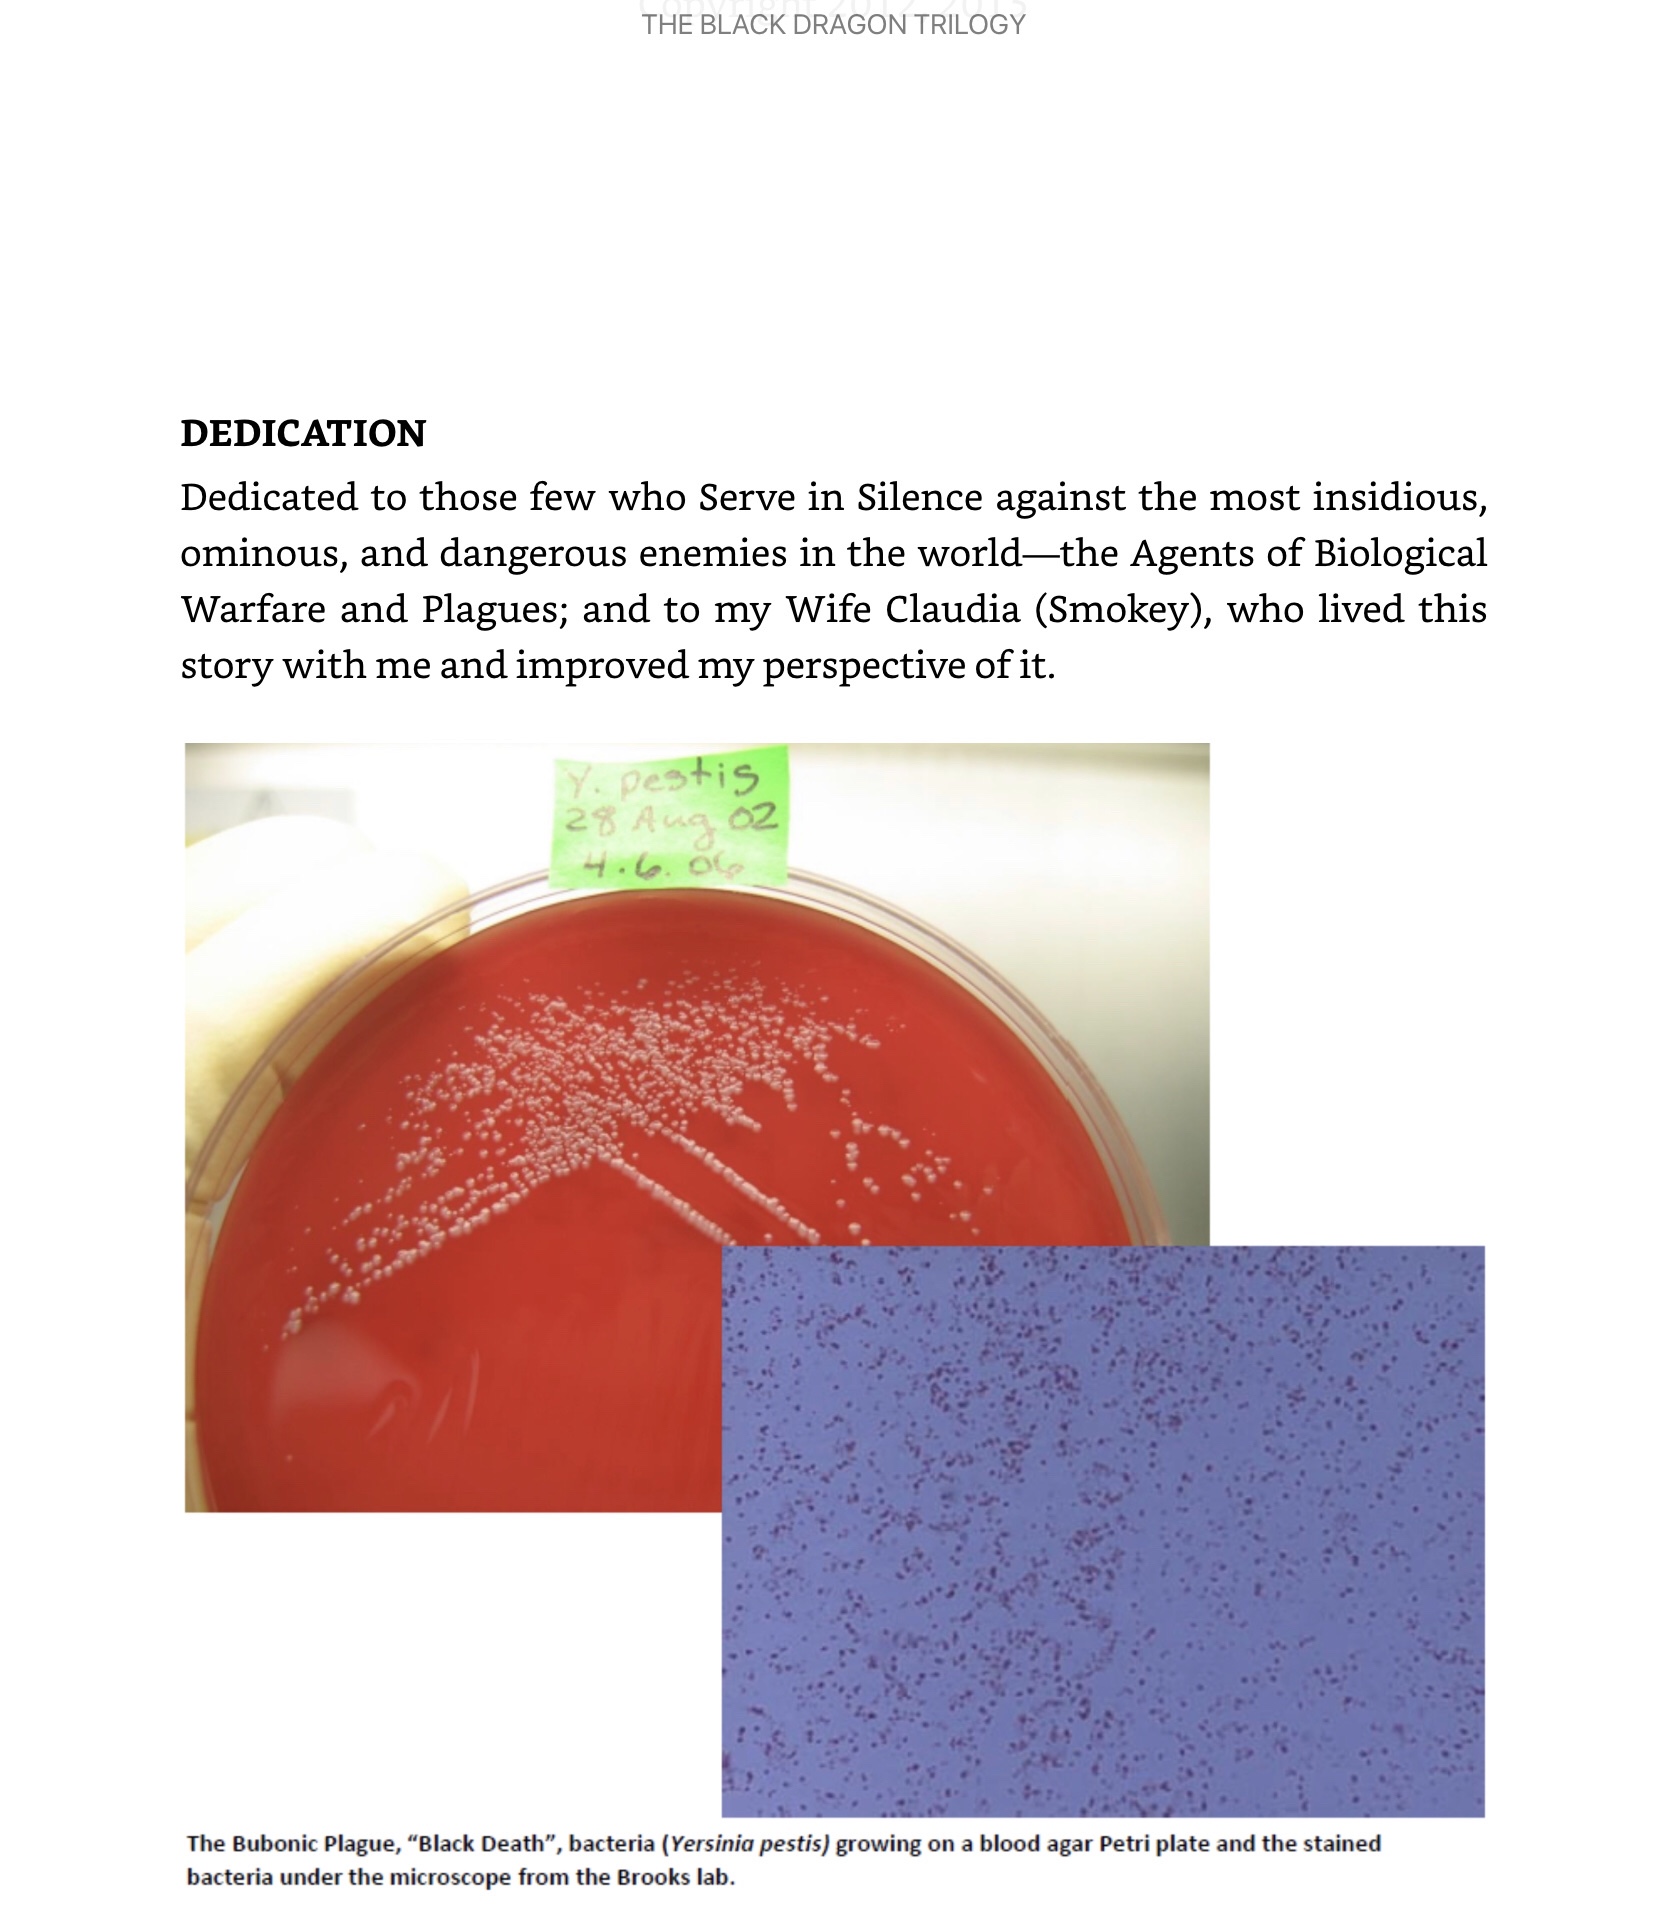

Dr Kiel served 35 years of combined active duty military (13 years, completed as a Major, Regular USAF, Biomedical Sciences Corps) and civilian service (22 years) in the Air Force, until May 2011. Before that he was a 2nd Lt, from Jan 1973 till April 1975, in USAF Reserves, Medical Services Corps, Texas A&M, Veterinary School. He was a Base Veterinarian (Captain, Veterinary Corps) from 1975 until 1977 caring for 25 military working dogs, military member and dependent owned animals, and USAF stabled horses. He taught pathogenic bacteriology at Texas A&M University School of Veterinary Medicine from 1974 until April 1975 when he entered military active duty. He received his PhD in Microbiology and Biochemistry from Texas Tech Health Sciences Center, Medical School, in 1981. Before receiving his PhD from Texas Tech Medical School, the USAF Veterinary Corps was disbanded in April 1980 and he entered the Biomedical Science Corps. He retired May 2011 at the level of Senior Scientist in the Senior Executive Service, a civilian equivalent of a Brigadier General. During his tenure at the Air Force Research Laboratory and School of Aerospace Medicine, he taught veterinarians, physicians, nurses, medical and entomological technicians about snake venom toxicology, field and medical treatments of the associated injuries, and infectious disease such as anthrax as part of Force Health Protection continuing education (approved as veterinary, medical and nursing CE for licensure). During his time with the USAF, he also consulted on and treated many snake and other reptile clinical cases and wrote articles and book chapters on their care and diseases. He also led a research team in basic research on non-ionizing radiation bioeffects, and in basic and applied research in biosurveillance and counterproliferation of Select Biological Agents (Especially Dangerous Pathogens) and other high-impact zoonotic diseases. His team fielded an identification and viability detection kit for all the Services for anthrax (and provided the initial field training), just in time for the first Iraqi War and recovered the last Bacillus anthracis out of Iraq before the second war in March of 2003. His team provided essential feedback to the CDC and Department of Defense on their Select Agent regulations, as far as their maintenance and oversight of transfer. He was a Responsible Official who oversaw the commissioning and operation of a BSL2+ and then a BSL-3 microbiological laboratory, both registered under the Select Agent Program from 5 Jan 2001 until July 2010 and implemented their closure due to the Base Realignment and Closure Act in 2010, helped design the new USAF BSL-3 facility at Wright-Patterson AFB, Ohio, and secured transfer of the biological agents to that laboratory. His team performed experiments involving plague, tularemia, Q fever, spotted fever and anthrax bacteria, and toxins and Select and non-Select emerging pathogenic agents with a perfect safety and security record from 1989 until the lab closure. His international collaborations extended from the United Kingdom, Australia, South Africa, Vietnam, Argentina, and France to the French West Indies (World Organisation for Animal Health (OIE) Heartwater Laboratory) and as a consultant to Southwest Research Institute as part of the DoD Cooperative Biological Engagement Program in Azerbaijan from 2011 to 2015 and Kazakhstan from 2015 until 2016. Dr Kiel received his BS and DVM, Summa Cum Laude, has been a Diplomate of the American College of Veterinary Microbiologists,since 1984 and was elected a Charter member of the specialty of Veterinary Parasitology in 2011. He is also a Fellow of the American Association for the Advancement of Science, elected 22 Sept 1995 and a Fellow of the Air Force Research Laboratory 21 Oct, elected in 1998. He has authored 106 publications including peer-reviewed journal articles, proceedings, government reports, book chapters, and four books; he is an inventor and holder of 30 US patents. July 2015 until March 2017, he practiced full time small animal, pocket pet, rabbit and reptile veterinary medicine. From July 2017 until present, he does veterinary practice part time at cat and dog outdoor mobile vaccine and anti-parasite clinics in the Texas summer heat, winter cold, rain, storms and occasional hurricane.










Teaching about venomous snakes and their behaviors and dealing with snakebite in the field:






My many travels for the Counterproliferation Mission:

I leave you with this:

